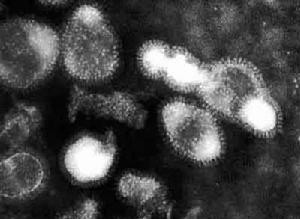
（圖）H1N1亞型豬流感病毒

H1N1亞型豬流感病毒
H1N1亞型豬流感病毒命名來源
H1N1亞型豬流感病毒
H1N1亞型豬流感病毒根據流感病毒感染的對象,可以將病毒分為人類流感病毒、豬流感病毒、馬流感病毒以及禽流感病毒等類群,其中人類流感病毒根據其核蛋白的抗原性可以分為三類:
甲型流感病毒(Influenza A virus),又稱A型流感病毒
乙型流感病毒(Influenza B virus),又稱B型流感病毒
丙型流感病毒(Influenza C virus),又稱C型流感病毒
感染鳥類、豬等其他動物的流感病毒,其核蛋白的抗原性與人甲型流感病毒相同,但是由於甲型、乙型和丙型流感病毒的分類只是針對人流感病毒的,因此通常不將禽流感病毒等非人類宿主的流感病毒稱作甲型流感病毒。
在核蛋白抗原性的基礎上,流感病毒還根據血凝素和神經氨酸酶的抗原性分為不同的亞型。
根據世界衛生組織1980年通過的流感病毒毒株命名法修正案,流感毒株的命名包含6個要素:型別/宿主/分離地區/毒株序號/分離年份(HnNn),其中對於人類流感病毒,省略宿主信息,對於乙型和丙型流感病毒省略亞型信息。例如A/swine/Lowa/15/30(H1N1)表示的是核蛋白為A型的,1930年在lowa分離的以豬為宿主的H1N1亞型流感病毒毒株,其毒株序號為15,這也是人類分離的第一支流感病毒毒株。
病毒分離
 H1N1亞型豬流感病毒分離結果
H1N1亞型豬流感病毒分離結果利用8質粒拯救系統成功拯救出了豬流感病毒毒株A/Swine/TianJin/01/2004(H1N1)(A/S/TJ/04)。將豬流感病毒8個基因節段經RT-PCR合成cDNA後,分別克隆到RNA聚合酶I/II雙向表達載體PHW2000中,構建成8個重組質粒。用8個重組質粒共轉染COS-1細胞,30h後加入TPCK-胰酶至終濃度0.5μg/mL。
共轉染48小時後收穫COS-1細胞及其上清,經尿囊腔接種9日齡SPF雞胚。收穫死亡雞胚尿囊液並繼續用SPF雞胚傳3代,得到有感染性的病毒。經血凝、血凝抑制驗、測序分析、電鏡觀察等均證實了A/S/TJ/04豬流感病毒的成功拯救。
這是中國首次拯救出H1N1亞型豬流感病毒,為進一步研究豬流感病毒基因組結構與功能的關係、流感跨種傳播的機制以及構建新型豬流感疫苗株奠定了基礎。
與其他幾個亞型
 H1N1亞型豬流感病毒
H1N1亞型豬流感病毒豬流感病毒(Swine influenza virus,SIV),是豬群中一種可引起地方性流行性感冒的正黏液病毒(Orthomyxoviruses)。目前在實驗室里所分離出來的病毒,多被辨識為C型流感病毒,或者是A型流感病毒的亞種之一。電子顯微鏡下的A型流感病毒豬流感有很多個不同的品種,計有:H1N1、H1N2、H3N1、H3N2和H2N3亞型的甲型流感病毒都能導致豬流感的感染。
對中國分離到的豬流感病毒和GenBank資料庫中已有的豬流感病毒H1N1、H1N2和H3N2亞型毒株的HA、NA基因核苷酸序列進行分析,分別選出各個病毒亞型HA和NA基因中高度保守且特異的核苷酸區域,設計擴增豬流感病毒H1和H3、N1和N2亞型的2套多重PCR特異性引物,建立了豬流感H1N1、H1N2和H3N2亞型病毒多重RT-PCR診斷方法。
採用該方法對H1N1、H1N2、H3N2亞型豬流感病毒標準參考株進行RT-PCR檢測,結果均呈陽性,對擴增得到的片段進行序列測定和BLAST比較,表明為目的基因片。其它幾種常見豬病病毒和其它亞型豬流感病毒的RT-PCR擴增結果都呈陰性.對107 EID50/0.1 mL病毒進行稀釋,提取RNA進行敏感性試驗,RT-PCR最少可檢測到102 EID50的病毒量核酸。
對40份陽性臨床樣品的檢測結果是H1N1、H1N2和H3N2亞型分別為16份、1份和20份,其它3份樣品同時含有H1N1和H3N2亞型豬流感病毒,和雞胚分離病毒結果100%一致。試驗證明建立的豬流感病毒H1N1、H1N2和H3N2亞型多重RT-PCR診斷方法是一種特異敏感的診斷方法,可用於臨床樣品的早期快速診斷和分型。
感染特性
H1N1亞型豬流感病毒引起的一種急性呼吸道傳染病極少傳染給人。人感染豬流感病毒後,會出現高燒、精神不振、厭食、咳嗽等症狀。美國疾控中心官員曾指出,這種豬流感病毒毒株是一種奇特的混合體,包含人流感病毒、禽流感病毒和豬流感病毒的基因片段,感染者的症狀與普通流感病毒感染者類似。
傳播特點
世界衛生組織的專家警告稱,流感的不同之處就在於患者多為身體強壯的年輕人,而非一般流感容易感染到的老人和兒童等抵抗力較弱的對象,而這一點正是會造成大量死亡的嚴重流感特徵之一。資料顯示,在1918年暴發的全球性流感中,世界範圍內共有4000萬人死亡,而在疫情初期死亡的患者全都是身強力壯的青年人。
治療方法
 H1N1亞型豬流感病毒
H1N1亞型豬流感病毒醫學測試顯示,目前主流的抗病毒藥物對這種毒株有療效。目前醫學界還沒有研究出任何可以抵禦豬流感的疫苗,已經投入使用的流感疫苗是否能夠提供保護不得而知。
人感染豬流感的病例很少見,豬流感病毒幾乎不在人際間傳播。2005年12月至今年1月,美國只發現過12例人感染豬流感病例,其中11人與豬有過直接接觸。
世衛組織發表聲明說,他們正在儲備抗病毒藥“達菲”即磷酸奧司他韋(Oseltamivirphosphate),奧司他韋的磷酸鹽,化學物質登記號CASRN為204255-11-8 。這種藥物先前廣泛套用於防治禽流感,經測試也對這種新型豬流感病毒有效。
預防方法
 H1N1亞型豬流感病毒
H1N1亞型豬流感病毒因為H1N1亞型豬流感病毒跟人類H1N1病毒的抗原非常不同,所以季節性流感的疫苗不能為人類提供保護。豬流感對抵抗力差人士影響較大,正確的做法是儘量不要身體接觸,包括握手、親吻、共餐、不要混合使用餐具等。疫區外出活動應戴上口罩。生活中注意儘量少與人接觸,除非極其必要,否則應避開人群密集場所,不要參加人群聚集的活動。養成良好的個人衛生習慣,充足睡眠、勤於鍛鍊、減少壓力、足夠營養;勤洗手,尤其是接觸過公共物品後要先洗手再觸摸自己的眼睛、鼻子和嘴巴;打噴嚏和咳嗽的時候應該用紙巾捂住口鼻;室內保持通風等。如出現發熱症狀,應儘快到發熱門診就醫。如在境外出現流感樣症狀(發熱,咳嗽,流涕等),應立即就醫(就醫時應戴口罩),並向當地公共衛生機構和檢驗檢疫部門說明。為了防止感染,應採取以下措施:
1. 保持手部清潔,並用正確方法洗手。如沒有明顯污垢時,可用酒精搓手液消毒。
2. 避免手部接觸眼睛、鼻及口。
3. 打噴嚏或咳嗽時應遮掩口鼻。
4. 不要隨地吐痰,如要吐痰應將分泌物包好,棄置於有蓋垃圾箱內。
5. 有呼吸道感染症狀或發燒時,應戴上口罩,並儘早求醫。
6. 若出現流感症狀,切勿上班或上學。
7. 如外游途中或回程後出現發燒或類似流感的症狀,要馬上就醫,告知醫生有關外遊記錄。
與SARS的異同
 H1N1亞型豬流感病毒
H1N1亞型豬流感病毒相同點
1:都可以再人和人之間交叉感染,傳播途徑類似
2:感染的醫學比列相似(都為1:1——1:15)
3:都具有一點程度的普遍耐藥性,但不具備廣泛耐藥性
4:都是由動物傳播給人
5:都具有致命性,但都可得到有效控制治療
6:兩者都具有一點時間的潛伏期(SIV略短),且前期症狀都與普通疾病類似
7:都可通過合理的日常預防手段加以控制
不同點
1:SIV的基因片段更加複雜,是一種變異病毒(原本的SIV不可以在人際間傳播)
2:SIV的易感染人群為青少年及其中壯年,這點非常特殊
3:SIV對目前的四種抗流感病毒藥中的兩種無效
4:SIV病患的症狀各不相同,這與常見傳染類疾病大相逕庭
